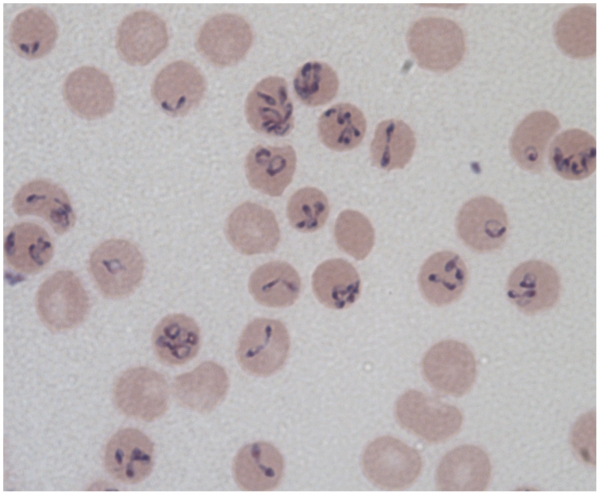

Deprecated: implode(): Passing glue string after array is deprecated. Swap the parameters in /home/nd07e65/socialdogcat.com/plugins/content/adsinside/adsinside.php on line 180
Deprecated: implode(): Passing glue string after array is deprecated. Swap the parameters in /home/nd07e65/socialdogcat.com/plugins/content/adsinside/adsinside.php on line 205
La babesiosi nel cane e nel gatto
La babesiosi, conosciuta anche come pirpolasmosi, è una malattia parassitaria che interessa i cani ma può occasionalmente colpire anche i gatti e l'uomo. Si tratta di un microrganismo molto piccolo, che in relazione all'animale che infetta può causare danni praticamente inesistenti o può portare a morte in tempi brevissimi.
È molto importante accorgersi dei sintomi e condurre il prima possibile il nostro cane da un medico veterinario che somministrerà tempestivamente un farmaco in grado di distruggere in breve tempo il parassita.
Che cos'è e come si trasmette
La Babesia, genere di parassita le cui specie più comuni sono Babesia canis per il cane, Babesia cati e Babesia felis per il gatto, sono dei piccoli protozoi che penetrano nell'organismo dell'animale ed entrano all'interno dei globuli rossi, le cellule che conferiscono il tipico colore al sangue e il cui scopo è quello di trasportare ossigeno per tutto l'organismo.
La babesia è lunga circa la metà di un globulo rosso (che misura 0,007 mm di circonferenza) e una volta entrata nel globulo si riproduce una prima volta, quindi da un organismo se ne formano due; poi tentano di riprodursi, ma divenendo quattro sono troppe per un globulo rosso, che "esplode" e muore. Le quattro babesie parassitano ciascuna un altro globulo rosso, si riproducono di nuovo e così via.
La trasmissione avviene direttamente all'interno del sangue, ad opera di una zecca, animale che si trova comunemente nell'erba e che si nutre del sangue degli animali domestici.
Se una zecca infetta morde il nostro animale, passerà l'infezione e il nostro cane o gatto, oltre ad accusarne i sintomi, diventa in grado di trasmetterla a sua volta ad altri animali.
Se una zecca sana, infatti, morde il nostro cane o il nostro gatto e assume le babesie, quando morderà un altro animale trasmetterà l'infezione. Ma non finisce qui: le zecche figlie di una zecca infetta nascono già con le babesie all'interno dell'organismo, per cui saranno infettanti per tutta la vita.
Un'altra via di trasmissione, meno comune, è quella della trasfusione di sangue. Generalmente i centri trasfusionali controllano l'assenza delle infezioni nel sangue del donatore (esattamente come avviene con il sangue umano con le donazioni) ma se questo procedimento viene saltato in cliniche negligenti il nostro cane potrebbe contrarre l'infezione.
Che cosa fa
Abbiamo già parlato del particolare meccanismo di azione del parassita: penetra nei globuli rossi e, di fatto, li distrugge.
Il sistema immunitario del cane cerca di limitare l'infezione nel momento in cui le babesie sono ancora fuori dal globulo rosso, visto che non possono riprodursi se non sono all'interno. Se il cane o il gatto sta bene ed ha un sistema immunitario ben funzionante la malattia potrebbe essere fermata sul nascere.
Nel caso invece di cuccioli, che ancora non hanno un immunità ben sviluppata, di anziani oppure di soggetti compromessi magari da un'altra malattia, le conseguenze possono diventare più gravi.
In generale, la disponibilità di ossigeno diminuisce. I globuli rossi, infatti, si "stirano" per passare dai capillari polmonari, ma se hanno dentro il parassita diventano più rigidi e non riescono; questo crea dei veri e propri ingorghi di sangue prima del polmone, e l'ossigeno disponibile diminuirà. Questo va unito al fatto che distruggendo i globuli rossi, che lo trasportano nel sangue, di ossigeno ce ne sarà ancora meno.
Le mucose diventano di color giallastro a causa dell'eccessiva distruzione dei globuli rossi, e si osservano emorragie in varie parti del corpo dovute al fatto che le sostanze anticoagulanti si esauriscono molto rapidamente a causa della presenza del parassita.
I sintomi peggiori sono però la febbre, anche molto alta, la riluttanza al movimento, la stanchezza continua, l'anemia evidenziabile con delle semplici analisi del sangue, vomito e diarrea.
Nei cuccioli potrebbero verificarsi fenomeni allergici che possono essere anche mortali a causa dello shock, e si verificano in tempi brevissimi. Questi casi sono però piuttosto sporadici, mentre la sintomatologia descritta sopra è in assoluto la più frequente.
Come si cura e come si previene
La prevenzione di questa malattia è molto importante, anche perché si deve agire sulla via di trasmissione (le zecche) che sono in grado di trasmettere anche malattie più gravi.
Evitate l'erba alta, dove generalmente le zecche vivono, e fate molta attenzione al fatto che notare se l'animale si gratta e si morde in un punto ben preciso può far sì che riusciamo a staccare la zecca dalla pelle del nostro amico prima che riesca a trasferire i parassiti (non è una cosa immediata, deve comunque passare un po' di tempo "attaccata" prima che lo trasmetta).
Esistono anche prodotti repellenti in grado di tener lontane le zecche dalla pelle del nostro animale.
Nel caso in cui notassimo febbre (generalmente compare dopo un paio di settimane dal morso della zecca) e alcuni dei sintomi che abbiamo descritto (alziamo un labbro e vediamo se il rosa della mucosa è diventato bianco o tende un po' al giallastro) portiamo immediatamente l'animale da un veterinario, che somministrerà il giusto farmaco al cane per eliminare definitivamente la babesia dopo averne appurato la presenza tramite un semplice esame al microscopio dei globuli rossi (le babesie si vedono molto bene).
Da qualche anno è disponibile anche un vaccino, che non riesce a prevenire l'infezione ma riduce molto i sintomi: tuttavia l'efficacia non è ancora comprovata e per questo motivo sarebbe utile parlarne con il veterinario, in modo da sapere se, in relazione all'ambiente in cui l'animale vive, possa essere utile per evitare la babesiosi.